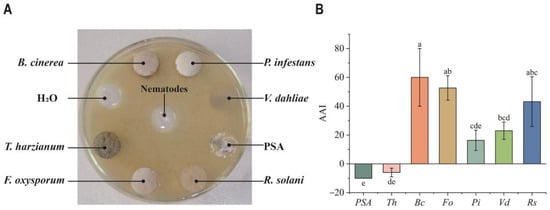

Abstract
In continuously cropped strawberry soil, a large population of the fungivorous nematode, Aphelenchus avenae, was observed to increase significantly over time. This nematode, which feeds on pathogenic fungi affecting strawberries, has significant potential as a biocontrol agent. The purpose of this article is to discuss the nematode’s preference for fungi associated with strawberries and its impact on the growth of strawberry roots. With the exception of Trichoderma harzianum, most of the pathogenic fungi commonly found in strawberry soil, such as Fusarium oxysporum, Rhizoctonia solani, Verticillium, Phytophthora infestans, and Botrytis cinerea Pers. attracted A. avenae and supported their propagation. All treatments with A. avenae and the non-nematode control showed a consistent trend throughout strawberry development, indicating that a moderate amount of A. avenae does not adversely affect strawberry roots. Moderate and low levels of A. avenae significantly increased the activity of antioxidant enzymes, superoxide dismutase (SOD), and peroxidase (POD) in strawberry roots in all treatments during the entire growth stages. Also, the malondialdehyde (MDA) content of strawberry roots in all nematode treatments was lower than that in the no-nematode control. Despite an overabundance of A. avenae, which negatively affected the redox system balance of strawberry roots, A. avenae can protect the roots from pathogenic fungi by preventing infection and damage. These results lay the foundation for the potential use of A. avenae as a biological agent to control these pathogenic fungi in strawberry soil, in combination with the biological fungi (T. harzianum).
1. Introduction
Aphelenchus avenae is a commonly found fungal-feeding nematode categorized within the order Aphelenchida and the family Aphelenchidae [1]. This nematode is ubiquitous in soil and has a broad range of fungal hosts, including saprophytic, pathogenic, and mycorrhizal fungi. Although A. avenae is frequently discovered in soil samples from the rhizospheres of diseased and healthy plants, it is widely considered to be incapable of attacking the healthy tissues of higher plants [2]. Even though A. avenae has been found in plant root tissues by early investigators, it has been suggested that this occurs as a result of the nematode feeding on an invading fungal pathogen or fungi associated with the plant [3].
As a fungal feeder, A. avenae has the potential to be used as a bio-control agent against soilborne fungal plant pathogens, primarily because it predominantly consumes phytopathogenic fungi [2]. Thus, many investigations have been conducted on the potential use of this nematode as a biological agent to combat soilborne fungal diseases [4]. Rhoades and Linford (1959) conducted the first systematic study and discovered that A. avenae effectively controlled Pythium root rot in maize (Zea mays L.) in greenhouse conditions. Additionally, A. avenae was found to suppress fusarium wilt in cotton and damping off in cauliflower seedlings caused by Rhizoctonia solani [5,6].
In our previous study, we found that the population of fungivorous nematodes increased over time. This is likely due to a general rise in fungal populations, which thrive in soil with more favorable moisture levels in continuously cropped strawberry fields. We systematically identified the dominant fungivorous nematode using both traditional morphology and molecular biology methods. It was classified as a variant of A. avenae. This variant, known as an isolate A. avenae, is recognized as a biological agent for controlling soil-borne plant pathogens and can consume various plant-pathogenic fungi [1,4]. However, there is currently limited information available about the preference of A. avenae for the fungi associated with strawberries. Given the significant presence of A. avenae in the rhizosphere soil of continuously cropped strawberry fields, further research is necessary to understand its fungal-feeding habits and its impact on the growth of strawberry plants.
Therefore, the objectives of this study are to (i) examine the fungi preferences of A. avenae and its population growth rates when fed different types of fungi and (ii) to investigate the impact of varying A. avenae population levels on strawberry root by examining root activity and the activity of root defense enzymes such as SOD (superoxide dismutase), POD (peroxidase), and MAD (malondialdehyde), which is the end product of lipid peroxidation in biomembrane.
2. Materials and Methods
2.1. Biological Material
Nematodes: The isolate of A. avenae employed in the present study was collected from the soil of a strawberry farm in Haidian District, Beijing, China (38°54′ N, 116°23′ E). These nematodes were obtained from our stock culture, which consists of a line of descendants from a single female. The A. avenae nematodes were cultured on a fungal mat of Botrytis cinerea growing on a 1/5 strength medium of potato dextrose agar (PDA) (potato 40 g, dextrose 4 g, agar 15 g) in a 9 cm diameter Petri dish for 2–3 weeks at 25 °C. They were then extracted for 3 h at 25 °C using the modified Baermann funnel technique. The collected A. avenae nematodes were surface-sterilized using streptomycin sulfate (1000 ppm) for 30 min and kept at 5 °C in distilled water for 2 to 3 days until use as nematode inoculation.
Host fungi: The fungal isolates tested as hosts were Fusarium oxysporum Schlecht. f. sp. Fragariae Wiinks et Willams, Rhizoctonia solani Kuhm, Verticillium dahliae Klebahn, Phytophthora infestans Mont. de Bary, Botrytis cinerea Pers., and Trichoderma harzianum Rifai, all of which were provided from our stock cultures. Prior to the use of these fungi as hosts, they were cultured on 1/5 strength PDA at 25 °C (relative humidity: 70 ± 2%) and kept at 5 °C until use as fungal inoculation.
2.2. Food Selection of Nematodes on Fungus Hyphae
As a food source, the fungal mats, with a diameter of 7 mm, were removed from the PDA agar plates along with the corresponding host fungi using a sterilized centrifuge tube. On the test PDA agar plates (diam. 10 cm), one equidistant circle (diam. 7 mm) was cut out in the middle, and nine equidistant circles (diam. 7 mm), which were 40 mm from the middle one were cut out around the Petri dish, using a sterilized centrifuge tube. Fungal mats were randomly placed in the cavities of the nine circles around the Petri dish, with each one filled with different food sources (the seven host fungal mats), equivalent agar, and water, which served as a control treatment.
Then, 2400 active A. avenae (third-stage larvae) in 500 μL suspension were quickly transferred to the middle circle of the Petri dish. Each dish was sealed with laboratory film and kept at 25 °C [7]. The number of A. avenae that moved into the cavities with the fungal mats was recorded after 24 h using a dissection microscope (80× magnification). Nematodes accumulating in experimental fungal mats were compared to the cavity with water by calculating the attracting activity indices (AAI) [8,9]. For this statistic, AAI = 10 × (Nt-Nc)/Nc, where Nt = nematode numbers in the treatment group, Nc = nematode numbers in the control group, and the sign of the index reflects positive or negative accumulation for the treatment relative to the control [10]. Ten replicates were prepared in this manner. The Kruskal–Wallis one-way analysis of variance (ANOVA) on median ranks and Tukey’s multiple range test were calculated (SigmaStat 2.0, Statistical Package for the Social Sciences, SPSS, Chicago, IL, USA).
2.3. Propagation of Nematodes on Fungus Hyphae
The fungal mats (10 mm in diameter) of F. oxysporum, R. solani, V. dahliae, P. infestans, B. cinerea, and T. harzianum were grown on 1/5 strength PDA media in 9 cm diameter Petri dishes. Potato sucrose agar (PSA) medium was used as a blank control. These mats were then inoculated with A. avenae (third-stage larvae) at three different densities—10, 20, and 40 nematodes per dish. After 7, 14, and 21 days at a temperature of 25 °C in dark culture with a relative humidity of 70 ± 2%, the nematodes were extracted using the Baermann funnel technique and counted. The experiment was performed twice with five replicates (10, 20, and 40 per dish). This entire process was repeated ten times. Data were power-transformed to correct for variance inequality and then subjected to a two-way ANOVA with fungal and nematode isolates as factors. Subsequently, Tukey’s multiple range test was used to separate population growth [1].
2.4. Effect of Nematodes on Strawberry Root
Pot experiments were carried out to study the impact of A. avenae on strawberry roots. Uniformly and robustly grown 21-day-old strawberry seedlings (Fragaria × ananassa Duch. cv. ‘Benihoppe’) were individually transplanted into polyethylene pots (bottom diameter: 16 cm; top diameter: 15 cm; height: 11 cm) containing 2 kg soil (organic matter: 28.75 g/kg, total nitrogen: 1.32 g/kg, pH: 7.16). Meanwhile, strawberry seedlings were randomly selected and inoculated with different quantities of third-stage A. avenae nematodes (100, 200, 400, 800, and 1600 per pot), following procedures described elsewhere [11,12]. The pots were then randomly placed in a greenhouse with temperatures ranging from 25 °C to 28 °C during the day and 7 °C at night, with a relative humidity of 60% to 80%.
To monitor the condition of the strawberry roots, root sections were collected four times during the growing seasons of the strawberries: 6 September 2016 (seedling period), 10 November 2016 (blooming period), 5 January 2017 (young fruiting period), and 12 February 2017 (fruit harvesting period) [12]. For the assay of root activity and root defense enzyme activities, fresh strawberry roots were collected from nine individuals of each treatment at each sampling time. The roots were carefully washed with distilled water before being stored at 4 °C. The strawberry root tips (0.5 g; <2 cm) separated from three strawberry plants in each treatment were mixed as one replicate, and this process was conducted in three replicates.
Root activity was analyzed using the triphenyl tetrazolium chloride (TTC) method, as described by Li et al., and expressed as TTC reduction intensity using the following formula: Root activity = amount of TTC reduction (mg)/[fresh root weight (g) × time (h)] [12].
The SOD activity was measured using the nitrotetrazolium blue chloride (NBT) method, according to Gay and Tuzun. The activity was calculated as follows:
where ΔA560 is the decrease in absorbance at 560 nm (%), FW is the fresh weight, N is the dilution ratio, W is the weight of the sample (g), and T is the reaction time (min). For the POD assay, the guaiacol method outlined by Liu et al. was followed [13]. One unit (U) of POD activity was defined as the increase in absorbance by 0.01 per minute. POD activity was determined using the following formula [14]:
where ΔA470 is the change in absorbance within 2 min, W is the weight of roots (g), T is the reaction duration (min), Vt is the total volume of extractive enzyme (mL), and Vs is the volume of determined enzyme (mL). MDA content was measured by the thiobarbituric acid (TBA) method, as previously described by Wang et al. It can be calculated as follows:
where W is the material weight (g) and V is the reaction time (min).
ASOD [U/g (FW)] = (ΔA560 × N)/(50% × WT)
APOD [U/g(FW)] = (ΔA470 × Vt)/(W × Vs × 0.01 × T)
MDA content [μmol/g (FW)] = [6.45 (A532 − A600) − 0.56A450] × V/W
2.5. Statistical Analysis
Nematode propagation data were power-transformed to correct for inequality of variance and subjected to a two-way ANOVA with fungal and nematode isolates as factors. Then, Tukey’s multiple range test was conducted to separate population growth rates [1].
Food selection data were calculated using a Kruskal–Wallis one-way ANOVA on median ranks and Tukey’s multiple range test (SigmaStat 2.0, SPSS, Chicago, IL, USA) [10].
Root data underwent a one-way ANOVA, and the means were compared using Tukey’s multiple range test in SPSS 17.0 (SPSS Inc., Chicago, IL, USA). Significant differences were considered at p < 0.05.
3. Results
3.1. Food Preference of Nematodes on Fungus Hyphae
Figure 1 illustrates the food preference of A. avenae on six types of fungus hyphae. After 24 h of culture, no A. avenae were found in the pure PSA cavity. The numbers of A. avenae that moved into the cavities with different fungal mats and water varied significantly. The attracting activity indices (AAI) value of T. harzianum was negative, while the AAI values of other fungi were positive. Moreover, the AAI value of B. cinerea was the highest of all (p < 0.05).
Figure 1.
Food preferences of fungivorous nematode Aphelenchus avenae. (A) Schematic diagram of the device used to conduct food preference experiments. (B) The attracting activity indices (AAI) of six fungi. PSA, potato sucrose agar. Bc, B. cinerea. Th, T. harzianum. Fo, F. oxysporum. Pi, P. infestans. Vd, V. dahlia. Rs, R. solani. Within each type of fungus, different letters above bars indicate statistical significance (Tukey’s test p < 0.05).
3.2. Propagation of Nematodes on Fungus Hyphae
In Figure 2, the effects of six fungal isolates on A. avenae’s population growth over 21 days are depicted. The population of A. avenae grew the fastest on B. cinerea hyphae when 10 and 20 nematodes were inoculated per dish (Figure 2A). The population growth rates of A. avenae were also high on R. solani and P. infestans. When 40 nematodes were inoculated per dish, A. avenae reproduced fastest on B. cinerea and R. solani hyphae after 21 days of culture. Furthermore, A. avenae exhibited very slow growth on T. harzianum, F. oxysporum and V. dahlia over the entire 21-day period. In contrast, on B. cinerea, R. solani, and P. infestans, A. avenae initially grew slowly during the first 14 days, but then accelerated significantly from day 14 to day 21.

Figure 2.
Growth model of A. avenae populations across different fungal hosts at 10 (A), 20 (B), and 40 (C) initial inoculations. Bc, B. cinerea. Th, T. harzianum. Fo, F. oxysporum. Pi, P. infestans. Vd, V. dahlia. Rs, R. solani. The population growth curve was fitted using the Gompertz model. Within each type of fungus, asterisks denote statistically significant differences indicate statistical significance (Tukey’s test, **** p < 0.0001), while “ns” indicates no significant difference.
3.3. Effect of Nematodes on Strawberry Root Growth
The root dry weight showed a consistent increase for all treatments and the no-nematode control as the strawberry plants grew, with a slightly declining growth rate at the fruit harvest stage. The root dry weights of the A-100 and A-1600 treatments were not significantly lower than that of the no-nematode control throughout all four growth stages of strawberry development (Figure 3A). In the final harvest stage, A-100 and A-200 were not significantly different from the control group, while A-400 and A-1600 were significantly higher than the control by 4.9% and 27.7%, respectively. In contrast, A-800 was significantly lower than the control by 6.8%.

Figure 3.
Effect of A. avenae on strawberry root growth (A) and root activity (B) throughout full development. CK represents the control group, and the numbers of different treatments indicate the number of inoculations. Within each treatment in the same period, different letters above bars indicate statistical significance (Tukey’s test p < 0.05).
The root activity decreased sharply from the seedling stage to the squaring stage for all treatments and the no-nematode control. The level remained consistently low from the squaring stage until the fruit harvest stage. The root activity of the no-nematode control was not significantly different from the A-100, A-200, A-800, and A-1600 treatments, while the A-400 treatment exhibited higher root activity compared to the other treatments (Figure 3B).
3.4. Effect of Nematodes on SOD Activity, POD Activity, and MDA Contents of Strawberry Root
In Figure 4, it can be observed that the SOD activity of the strawberry roots in all treatments and the no-nematode control demonstrated a rapid increase from the seedling stage to the squaring stage. After that, the SOD activity decreased gradually as the strawberries continued to grow, except for the A-200 treatment, which showed only a small decrease at the fruit harvest stage. Overall, higher SOD activity was observed in the A-200 and A-400 treatments, while no-nematode control and the A-1600 treatment exhibited lower root SOD activity (Figure 4A). All treatments with A. avenae and the non-nematode control showed no significant differences in the squaring and young fruit stages. However, in the seedling stage, SOD activities in the A-100, A-200, and A-400 treatments were significantly higher than in the control group, with A-200 also showing higher SOD activity than the control during the harvesting stage.

Figure 4.
Effects of A. avenae on SOD activity (A), POD activity (B), and MDA (C) contents in the roots of strawberries throughout the entire growth process. CK represents the control group, and the numbers of different treatments indicate the number of inoculations. Within each treatment in the same period, different letters above bars indicate statistical significance (Tukey’s test p < 0.05).
From the seedling stage to the squaring stage, the POD activity of the strawberry roots in both the control group and the A-100 treatment reached its peak at around 0.45·g−1 but decreased quickly at the fruit harvest stage (Figure 4B). However, the POD activity of the strawberry roots in the higher-dosage A. avenae inoculation treatments (A-800 and A-1600) decreased slowly throughout the entire growing stage. A. avenae enhances the root POD activity throughout strawberry development, except during the young fruit stage. In the seedling stage, POD activities were significantly higher in the A-200, A-400, A-800, and A-1600 treatments compared to the control group. This trend continued in the squaring and harvesting stages, with all treatments displaying increased POD activities relative to the control group.
The MDA content in the no-nematode control was consistently higher throughout the growth stages compared to the other treatments. There were minimal changes in MDA content from the seedling stage to the squaring stage, followed by a rapid decrease at the harvest stage. Both the A-400 and A-800 treatments exhibited a similar pattern of change in MDA content compared to the no-nematode control. However, the MDA content of A-100 and A-200 treatments first dropped to the valley at the squaring stage and climbed up to the peak at the young fruiting stage, followed by a small decrease at the fruit harvesting stage (Figure 4C). From the seedling stage to the squaring stage, MDA activity in all treatments, except for A-400, was significantly lower than that of the control group. During the young fruit stage, MDA activity in all treatments was also significantly lower than in the control group. At the harvesting stage, MDA activity in treatments A-400 and A-800 was significantly lower than the control group, which had the highest MDA activity overall.
4. Discussion
The classification of each nematode taxon to its feeding habits is crucial for analyzing nematode communities. A. avenae is a non-parasitic, fungivorous nematode commonly found in farmlands worldwide. It is important to study their fungus-eating behaviors thoroughly to understand the ecological role of A. avenae and to appropriately analyze soil nematode communities. A. avenae is a widespread fungivorous nematode and has been confirmed as a biological agent with potential to control soil-borne plant pathogens [15,16]. They have a high reproductive rate, a limited life cycle, a high capacity for colonization, and can be potentially problematic when disturbed. Considering that A. avenae thrives on fungi, the current study investigated the effectiveness of using A. avenae as a biological agent to control pathogenic fungi in strawberries [17].
In our study, we initially examined the preference of A. avenae for the fungi obtained from strawberries under controlled laboratory conditions. We observed that the nematode is attracted to and thrives on various types of strawberry fungi. Specifically, A. avenae showed a strong attraction to the fungal mats of three pathogenic fungi (F. oxysporum, R. solani, and B. cinerea) (Figure 1B), while being significantly repelled by T. harzianum. Moreover, A. avenae demonstrated a higher ability to reproduce by feeding on these three fungi, which are known to be serious pathogens in strawberry soil. For example, F. oxysporum can cause strawberry crown rot, leading to a significant impact on strawberry yield. Rhizoctonia spp. and the lesion nematode are mainly responsible for strawberry black root rot. Gray mold, caused by B. cinerea, is one of the most important diseases of field- and greenhouse-grown strawberries, resulting in significant yield losses [18]. Our findings are consistent with the statements made by researchers who noted that A. avenae can reproduce on many species of Fusarium [17,19]. This result lays the foundation for the potential use of A. avenae as a biological agent to control these pathogenic fungi in strawberry soil.
This attractiveness and ability to spread A. avenae indicate that it can feed on pathogenic fungi, and its population can be sustained in the field when A. avenae is applied (Figure 1 and Figure 2). Fungivorous nematodes have a mouth stylet that allows them to penetrate fungal cells and consume their contents, which damages the mycelium. Typically, soil population densities of fungivorous nematodes are lower than those of bacterivorous or phytoparasitic nematodes [20]. However, in the presence of suitable fungal hosts, their populations can multiply several times over a short period [21,22]. While the reasons for the limited attraction and poor population growth of T. harzianum are currently unknown, the fungal preference of A. avenae makes it feasible to use biocontrol fungi and biocontrol nematodes together.
In order to understand the impact of the fungivorous nematode A. avenae on the strawberry root system, we investigated the root dry weight and root activity of the strawberry plants from the seedling stage to the harvesting stage. Root dry weight across all treatments with A. avenae and the non-nematode control exhibited a consistent trend during strawberry development (Figure 3A). Initially, there was a modest increase in root dry weight from the seedling stage to the squaring stage. This was followed by a marked rise during the young fruit stage, after which the increase slowed, resulting in only a slight change leading up to the harvesting stage. The changes observed in the A-100, A-200, A-400, and A-800 treatment groups were within 7% compared to the control group. However, the root dry weight in the A-1600 treatment group increased by 27.7% compared to the control group. This indicates that a moderate number of nematodes does not significantly affect the dry weight of strawberry roots. In contrast, an excessive dosage can lead to abnormal growth of the roots. Additionally, the main difference in root activity between the treatment and control groups occurred primarily during the seedling stages (Figure 3B). These results show that the moderate application of A. avenae does not harm the root system of strawberries.
To establish a safety threshold for the number of A. avenae present, we further investigated how nematodes affect enzyme activities in strawberry roots. Antioxidant enzymes maintain a dynamic balance of reactive oxygen species (ROS) in plants. When plants experience stress, an increase in antioxidant enzyme activity helps prevent excessive ROS accumulation. In our study, we investigated changes in ROS-related enzymes in strawberry roots from the seedling stage to the harvesting stage. Antioxidant enzymes such as SOD and POD are primary H2O2 scavengers in mitochondria [23]. SOD is responsible for the initial removal of ROS, converting O2 to H2O2 [24]. Meanwhile, POD breaks down H2O2 into H2O, and it is crucial for lignin synthesis and ROS removal [24].
Moderate and low levels of A. avenae can significantly increase SOD and POD activity of strawberry roots in all treatments throughout the entire growth stages. However, when the number of A. avenae exceeds 1600 per pot, the SOD activity is significantly reduced in the seedling period. This is because the interference of the nematodes has surpassed the tolerance of the strawberry plants themselves, leading to an imbalance in the redox system.
MDA is the final product of a membrane peroxidation reaction, which can indicate the extent to which plants are affected by poisoning [25,26]. Throughout all the growing stages, the MDA content of strawberry roots in almost all nematode treatments was higher than that in the no-nematode control. This probably indicates that A. avenae, the fungivorous nematode, can protect the roots from pathogenic fungi, preventing them from infecting and damaging the roots. However, it is unclear whether the nematode is capable of penetrating healthy roots or whether it only attacks those already damaged by other causes, or those of weakened plants [27].
5. Conclusions
Considerable research has been dedicated to examining the behavior and ecological impact of the fungivorous nematode, Aphelenchoides avenae, particularly its interactions with the root systems of strawberry plants. This comprehensive study has revealed intriguing insights into the dietary preferences of A. avenae, demonstrating a strong attraction to specific pathogenic fungi, including Fusarium oxysporum, Rhizoctonia solani, and Botrytis cinerea. These fungi are known to cause diseases that result in significant yield losses in strawberry crops. Interestingly, while A. avenae actively targets and consumes these detrimental fungi, it displays a distinct aversion to Trichoderma harzianum, a fungus recognized for its beneficial effects on plant health and soil quality.
The implications of these findings are substantial, suggesting that A. avenae could be strategically employed in agricultural practices to mitigate the impact of pathogenic fungi on strawberry crops. The nematode’s natural predilection for consuming these pathogens presents an innovative, environmentally friendly approach to disease management in agriculture. However, the relationship between A. avenae and its host plants is complex. While its predatory activity provides protection against fungal infections, an uncontrolled population of A. avenae could potentially disrupt the delicate redox balance within the strawberry roots, which is essential for maintaining plant health and vigor. This underscores the need for careful management of A. avenae populations in agricultural settings.
Despite these challenges, the potential benefits of utilizing A. avenae as a biological control agent are significant. By naturally targeting and reducing populations of pathogenic fungi, A. avenae can contribute to healthier soil ecosystems and more robust strawberry plants. Furthermore, its aversion to T. harzianum suggests that A. avenae could play a role in maintaining or even enhancing the presence of beneficial fungi in the soil. This dual ability to control harmful pathogens while potentially supporting beneficial microorganisms underscores the versatility and potential of A. avenae as an ally in sustainable agriculture, offering a promising avenue for research and application in the management of soilborne diseases.
Author Contributions
X.L.: writing—original draft, project administration, funding acquisition, and data curation. A.C.: writing—review and editing and methodology. S.Z.: writing—review and editing, visualization, and formal analysis. H.Z.: writing—review and editing and investigation. Q.L.: conceptualization. W.Y.: writing—review and editing and supervision. J.Y.: data curation. C.C.: formal analysis. H.F.: investigation. All authors have read and agreed to the published version of the manuscript.
Funding
This research was funded by the National Natural Science Foundation of China (32402460), the National Key R&D Program of China (2019YFE0120400), and the National Nature Science Foundation of Sichuan Province (2022NSFSC0170).
Institutional Review Board Statement
Not applicable.
Informed Consent Statement
Not applicable.
Data Availability Statement
No new data were created or analyzed in this study. Data sharing is not applicable to this article.
Acknowledgments
We’d like to extend a heartfelt thank you to Qizhi Liu and her scientific team for generously providing the materials needed for this research. We gratefully thank anonymous reviewers for their valuable comments on the manuscript.
Conflicts of Interest
The authors declare no conflicts of interest.
References
- Okada, H.; Kadota, I. Host Status of 10 Fungal Isolates for Two Nematode Species, Filenchus misellus and Aphelenchus avenae. Soil Biol. 2003, 35, 1601–1607. [Google Scholar] [CrossRef]
- Karim, N.; Jones, J.T.; Okada, H.; Kikuchi, T. Analysis of Expressed Sequence Tags and Identification of Genes Encoding Cell-Wall-Degrading Enzymes from the Fungivorous Nematode Aphelenchus avenae. BMC Genom. 2009, 10, 525. [Google Scholar] [CrossRef] [PubMed]
- Barnes, G.L.; Russell, C.C.; Foster, W.D.; Barnes, G.L.; Russell, C.C.; Foster, W.D. Aphelenchus avenae, a Potential Biological Control Agent for Root Rot Fungi. Plant Dis. 1981, 655, 423–424. [Google Scholar] [CrossRef]
- Ishibashi, N.; Sachiko, T.; Eizo, K. Propagation and Feeding Behavior of the Mycetophagous Nematode, Aphelenchus avenae, on Four Species of Soil Fungi. Jpn. J. Nematol. 2005, 35, 13–19. [Google Scholar] [CrossRef]
- Karuri, H.W.; Amata, R.; Amugune, N.; Waturu, C. Interaction of Fusarium oxysporum f. Sp. Vasinfectum and the Fungal Feeding Nematode Aphelenchus avenae on Bt Cotton. J. Plant Pathol. 2014, 96, 183–188. [Google Scholar]
- Lagerlöf, J.; Insunza, V.; Lundegårdh, B.; Rämert, B. Interaction between a Fungal Plant Disease, Fungivorous Nematodes and Compost Suppressiveness. Acta Agric. Scand. Sect. B Plant Soil Sci. 2011, 61, 372–377. [Google Scholar] [CrossRef]
- Hedgecock, E.M.; Russell, R.L. Normal and Mutant Thermotaxis in the Nematode Caenorhabditis elegans. Proc. Nat. Acad. Sci. USA 1975, 72, 4061–4065. [Google Scholar] [CrossRef]
- Ishkawa, M.; Shuto, Y.; Watanabe, H. β-Myrcene, a Potent Attractant Component of Pine Wood for the Pine Wood Nematode, Bursaphelenchus xylophilus. Agric. Biol. Chem. 1986, 50, 1863–1866. [Google Scholar] [CrossRef][Green Version]
- Stamps, W.T.; Linit, M.J. Chemotactic Response of Propagative and Dispersal Forms of the Pinewood Nematode Bursaphelenchus xylophilus to Beetle and Pine Derived Compounds. Fundam. Appl. Nematol. 1998, 21, 243–250. [Google Scholar]
- Carta, L.K. Bacterial-Feeding Nematode Growth and Preference for Biocontrol Isolates of the Bacterium burkholderia Cepacia. J Nematol. 2000, 32, 362–369. [Google Scholar]
- Montes, M.J.; López-Braña, I.; Delibes, A. Root Enzyme Activities Associated with Resistance to Heterodera avenae Conferred by Gene Cre7 in a Wheat/Aegilops triuncialis Introgression Line. J. Plant Physiol. 2004, 161, 493–495. [Google Scholar] [CrossRef] [PubMed]
- Li, H.Q.; Zhang, L.L.; Jiang, X.W.; Liu, Q.Z. Allelopathic Effects of Phenolic Acids on the Growth and Physiological Characteristics of Strawberry Plants. Allelopath. J. 2015, 35, 61–76. [Google Scholar]
- Huang, X.-S.; Liu, J.-H.; Chen, X.-J. Overexpression of PtrABF Gene, a bZIP Transcription Factor Isolated from Poncirus trifoliata, Enhances Dehydration and Drought Tolerance in Tobacco via Scavenging ROS and Modulating Expression of Stress-Responsive Genes. BMC Plant Biol. 2010, 10, 230. [Google Scholar] [CrossRef] [PubMed]
- Polesskaya, O.G.; Kashirina, E.I.; Alekhina, N.D. Changes in the Activity of Antioxidant Enzymes in Wheat Leaves and Roots as a Function of Nitrogen Source and Supply. Russ. J. Plant Physiol. 2004, 51, 615–620. [Google Scholar] [CrossRef]
- Haraguchi, S.; Yoshiga, T. Potential of the Fungal Feeding Nematode Aphelenchus avenae to Control Fungi and the Plant Parasitic Nematode Ditylenchus Destructor Associated with Garlic. Biol. Control 2020, 143, 104203. [Google Scholar] [CrossRef]
- Azimi, S. Morphological and Molecular Characterization of Two Populations of Aphelenchus avenae (Nematoda: Aphelenchidae) from Iran and Their Phylogenetic Relationships. Biologia 2018, 73, 683–691. [Google Scholar] [CrossRef]
- Javed, S.; Khan, S. Mass Culturing of Mycetophagous Nematode Aphelenchus avenae (Nematoda: Aphelenchidae) in Vitro System by Feeding on Pathogenic Fungus. Sarhad J. Agric. 2021, 37, 675–682. [Google Scholar] [CrossRef]
- Veloukas, T.; Leroch, M.; Hahn, M.; Karaoglanidis, G.S. Detection and Molecular Characterization of Boscalid-Resistant Botrytis cinerea Isolates from Strawberry. Plant Dis. 2011, 95, 1302–1307. [Google Scholar] [CrossRef]
- EsaTaher, I.; Ami, S.N.; Haleem, R.A. First Record of Mycetophagous Nematode Aphelenchus avenae in Iraq with Description and Testing Their Propagation on Different Fungus Culture. Bull. Iraq Nat. Hist. Mus. 2017, 14, 251–259. [Google Scholar]
- Freckman, D.W.; Caswell, E.P. The Ecology of Nematodes in Agroecosystems. Annu. Rev. Phytopathol. 1985, 23, 275–296. [Google Scholar] [CrossRef]
- Hofman, T.W.; S’jacob, J.J. Distribution and Dynamics of Mycophagous and Microbivorous Nematodes in Potato Fields and Their Relationship to Some Food Sources. Ann. Appl. Biol. 1989, 115, 291–298. [Google Scholar] [CrossRef]
- Arancon, N.Q.; Galvis, P.; Edwards, C.; Yardim, E. The Trophic Diversity of Nematode Communities in Soils Treated with Vermicompost: The 7th International Symposium on Earthworm Ecology · Cardiff · Wales · 2002. Pedobiologia 2003, 47, 736–740. [Google Scholar]
- Foyer, C.H.; Baker, A.; Wright, M.; Sparkes, I.A.; Mhamdi, A.; Schippers, J.H.M.; Van Breusegem, F. On the Move: Redox-Dependent Protein Relocation in Plants. J. Exp. Bot. 2020, 71, 620–631. [Google Scholar] [CrossRef]
- Liu, D.; Wang, Y.; Zhang, X.; Si, Q. Effect of sewage irrigation on wheat growth and its activate oxygen metabolism. Ying Yong Sheng Tai Xue Bao 2002, 13, 1319–1322. [Google Scholar]
- Riaz, M. Boron Alleviates the Aluminum Toxicity in Trifoliate Orange by Regulating Antioxidant Defense System and Reducing Root Cell Injury. J. Environ. Manag. 2018, 208, 149–158. [Google Scholar] [CrossRef]
- Lv, Y.; Xu, J.; Xu, K.; Liu, X.; Guo, X.; Lu, S.; Xi, B. Accumulation Characteristics and Biological Response of Ginger to Sulfamethoxazole and Ofloxacin. Environ. Pollut. 2020, 262, 114203. [Google Scholar] [CrossRef]
- Kumari, S. Aphelenchus avenae (Nematoda: Aphelenchidae) under the Rhizosphere of Brassica napus. Helminthologia 2012, 49, 57–59. [Google Scholar] [CrossRef]
Disclaimer/Publisher’s Note: The statements, opinions and data contained in all publications are solely those of the individual author(s) and contributor(s) and not of MDPI and/or the editor(s). MDPI and/or the editor(s) disclaim responsibility for any injury to people or property resulting from any ideas, methods, instructions or products referred to in the content. |
© 2024 by the authors. Licensee MDPI, Basel, Switzerland. This article is an open access article distributed under the terms and conditions of the Creative Commons Attribution (CC BY) license (https://creativecommons.org/licenses/by/4.0/).